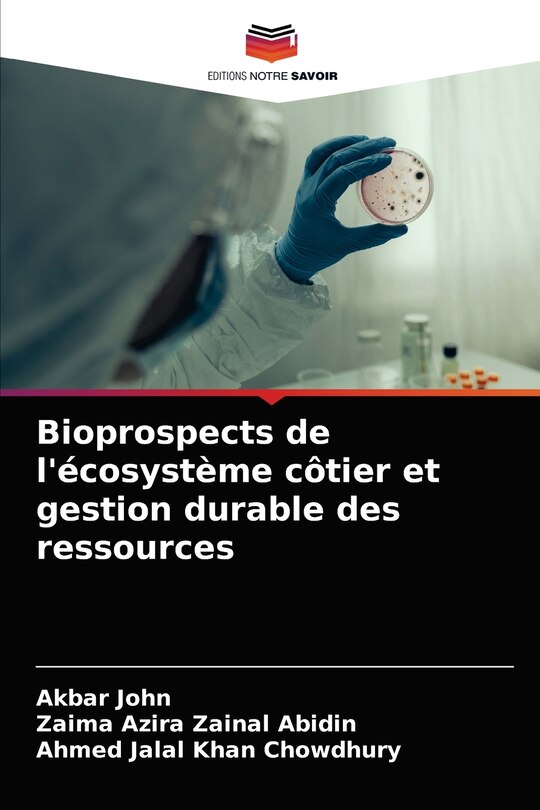

Aperçu gratuit du livre Bioprospects de l'écosystème côtier et gestion durable des ressources
45,50 $
Prix en ligne. Les prix et les offres peuvent différer en magasin.
M’expédier cet article
Vérification des stocks…
Acheter maintenant et ramasser en magasin
Vérification des stocks…
Trouver en magasin
Vérification des stocks…
Description
Publié par: KS Omniscriptum Publishing
Dimensions à l’expédition: 9" H x 6" W x 1" L
ISBN: 9786203507058
Étape de vie: null